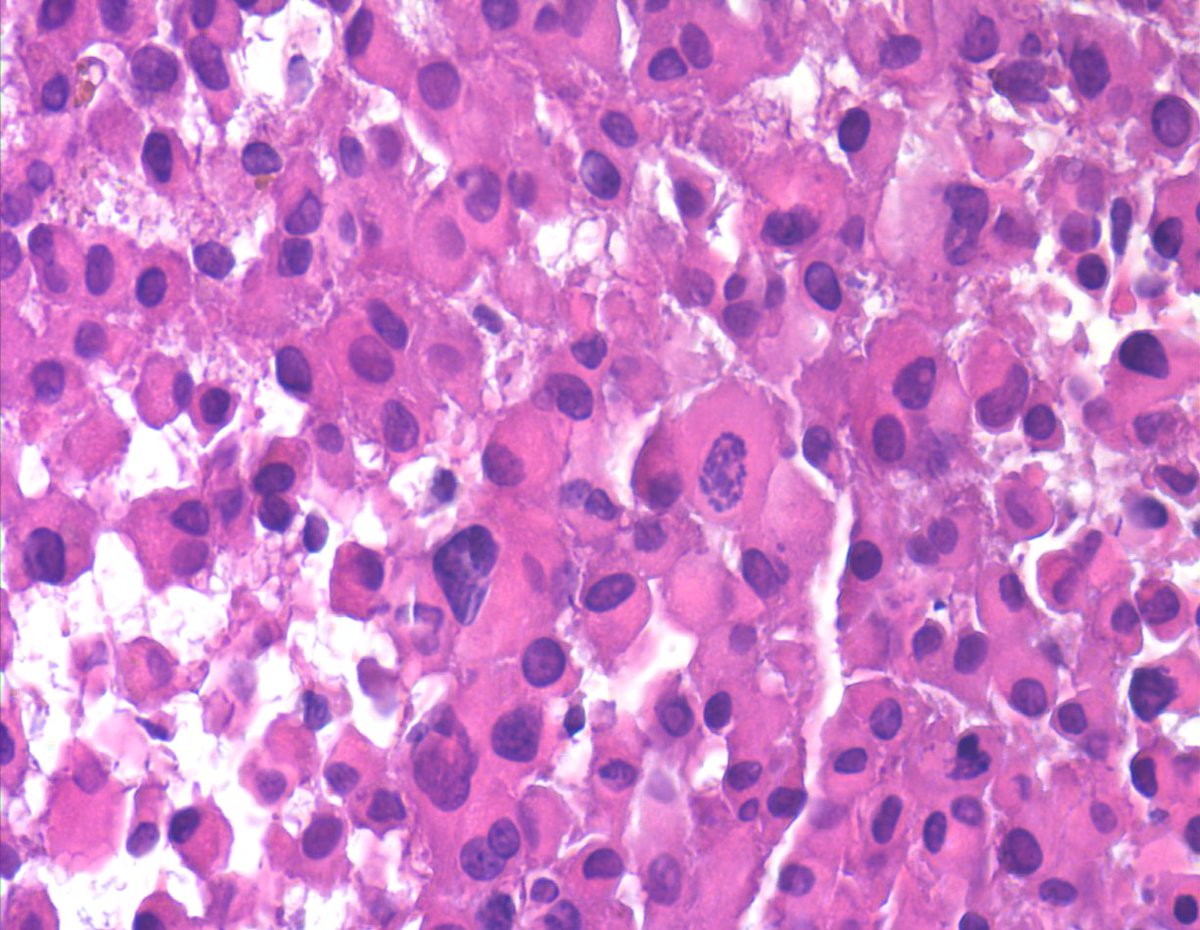
Soft tissue mass. NOT a met melanoma, Carcinoma or Mesothelioma. Most of you may only see 1-2 cases of this rare sarcoma in a lifetime of FNA practice. "Proximal-type Epithelioid Sarcoma - Epithelioid to rhabdoid cells, binucleation, macronucloli  and eosinophilic cytoplasm (CB).

LILIA M. BERNAL M
@dralmbernal
ID: 309317967
01-06-2011 22:08:02
3,3K Tweet
311 Followers
396 Following




1/ In honor of beautiful Barcelona, Catalunya, Spain, and my wonderful host Irene Sansano, MD Phd , I would like to start a new thread called "Plata" (silver) It will be all about the Grocott Methenamine Silver (GMS) stain. Let's start with Histoplasma



Another #Pathology infographic Gem 💎 from our Master Abhijit Das, MD much thanks!

Únete a esta gran iniciativa. Un espacio de crecimiento para todos! 💫💯🔊 SEAP-IAP European Society of Pathology (ESP) International Academy Cytology Young EFCS Ashish.Chandra Frida Rosenblum Andres Matoso @mercejorda2 UMiami Pathology Clínica Universidad de Navarra Tania Labiano Eduardo Alcaraz, MD PhD Héctor-Enrique Torres-Rivas, MD Sonsoles Aso Manso Syed Z. Ali Sociedad Española de Citología


Cannonballs: ductal carcinoma of the breast in a pleural effusion. "When cells read the book and follow the rules..." 😀💦🔬📚#cytopath International Academy Cytology Young EFCS





Our hiring at Mayo Clinic Florida Pathology continues apace! If you're a transfusion medicine specialist, or know someone who is, have a look! …wp-saasfaprod1.fa.ocs.oraclecloud.com/hcmUI/Candidat…






COMING SOON, the “Cells in Session”, an exciting new educational initiative of International Academy Cytology, organized by the “Leaders of Future” and “Cytotechnology Committees”. A monthly series of live teaching sessions emphasizing cellular morphology and diagnostics. cytology-iac.org/cells-in-sessi…